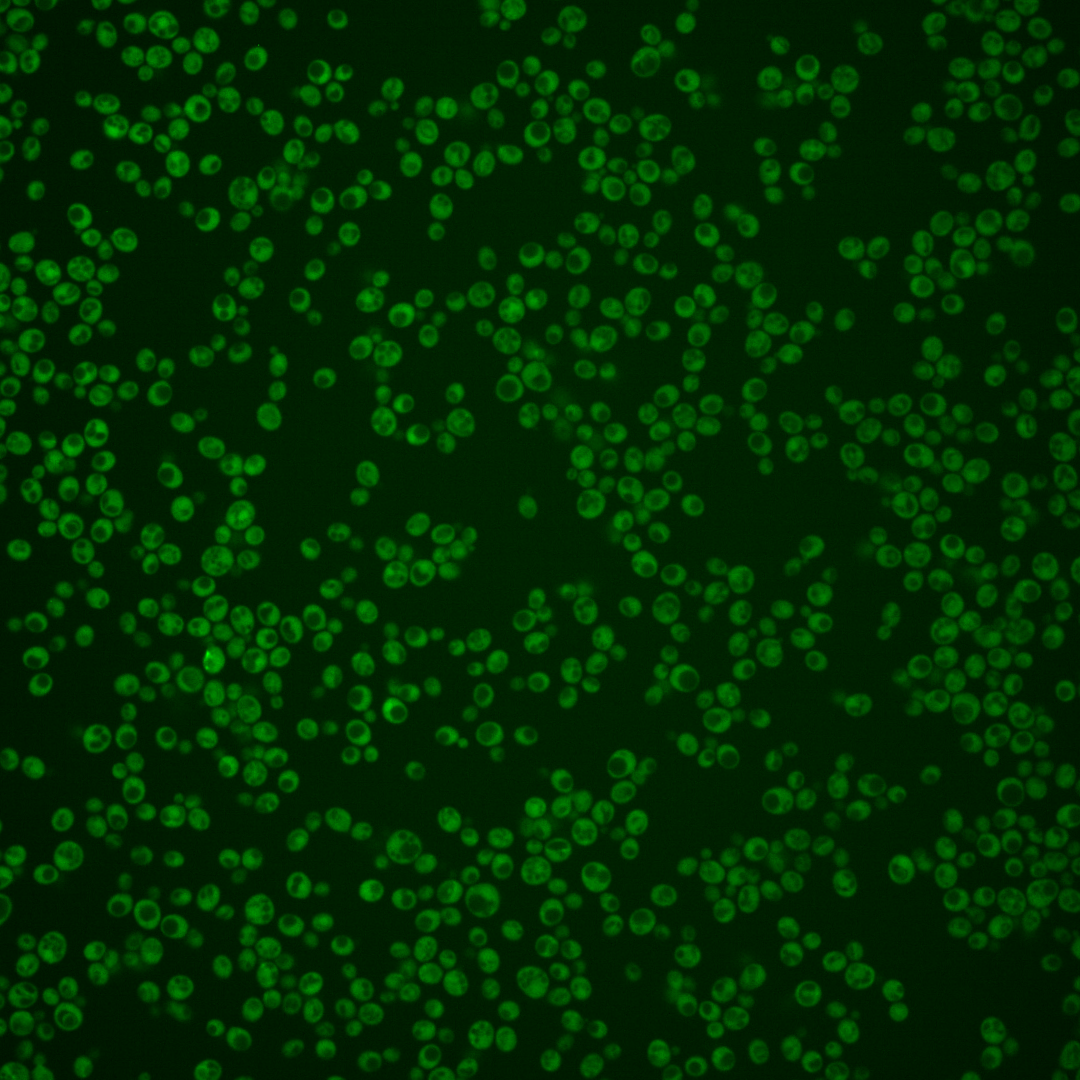
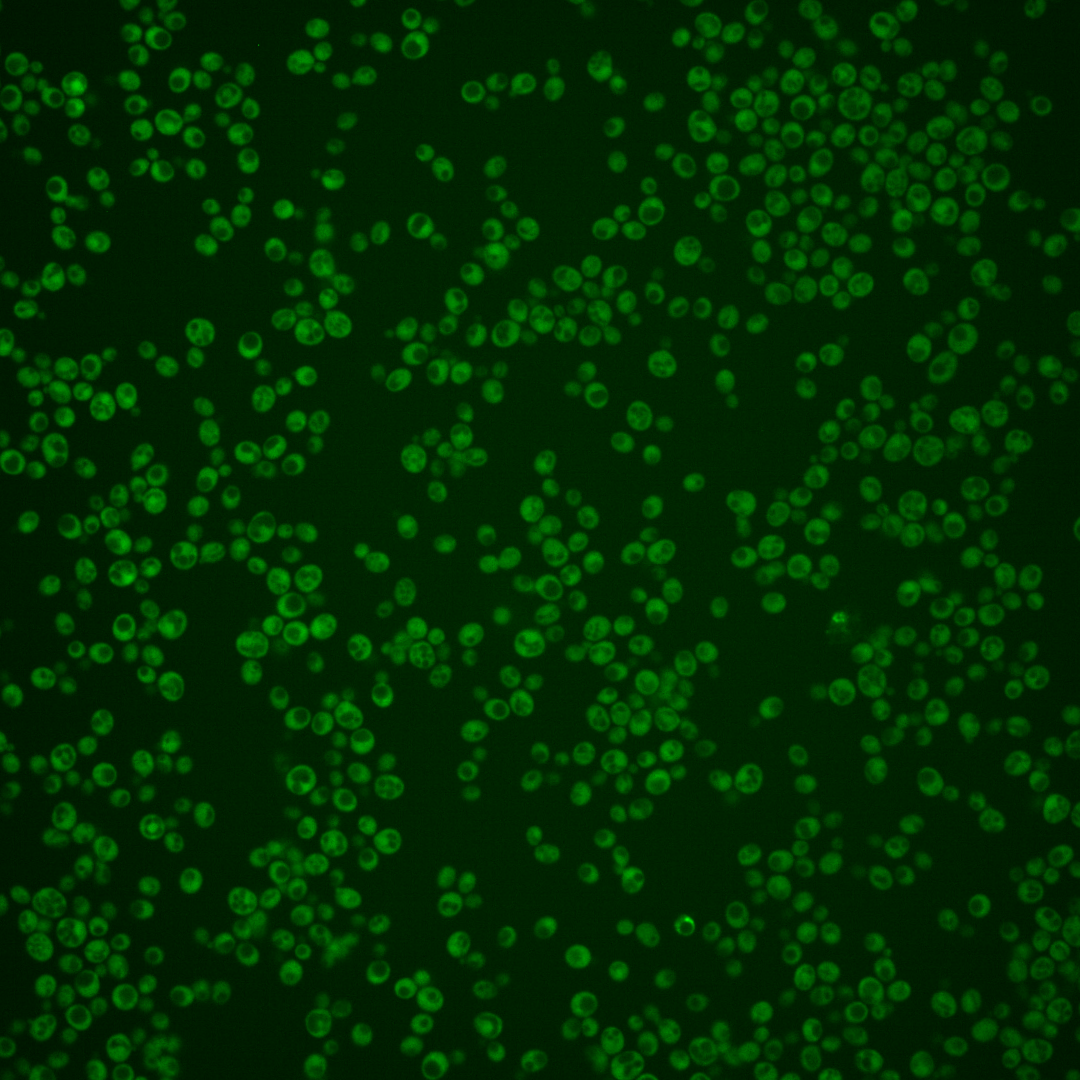

| ORF | |
|---|---|
| Human Ortholog | |
| Description | Putative protein of unknown function; GFP-fusion protein expression is induced in response to the DNA-damaging agent MMS |
Micrographs




















































































Sub-cellular Localization
Yeast GFP Assignment
Protein Abundance
Localization Change
External localization resources
| ensLOC | DeepLoc | |||||||||||||||||||||||
|---|---|---|---|---|---|---|---|---|---|---|---|---|---|---|---|---|---|---|---|---|---|---|---|---|
| Localization | WT1 | WT2 | WT3 | RAP60 | RAP140 | RAP220 | RAP300 | RAP380 | RAP460 | RAP540 | RAP620 | RAP700 | HU80 | HU120 | HU160 | rpd3Δ_1 | rpd3Δ_2 | rpd3Δ_3 | WT1 | WT2 | WT3 | AF100 | AF140 | AF180 |
| Cortical Patches | 0 | 0 | 0 | 0 | 0 | 0 | 0 | 0 | 0 | 0 | 1 | 1 | 0 | 0 | 0 | – | 0 | 0 | 0 | 0 | 0 | 0 | 0 | 1 |
| Bud | 2 | 1 | 1 | 1 | 0 | 0 | 0 | 1 | 9 | 5 | 3 | 1 | 0 | 0 | 0 | – | 0 | 1 | 0 | 0 | 0 | 0 | 2 | 4 |
| Bud Neck | 0 | 0 | 0 | 0 | 0 | 0 | 1 | 0 | 0 | 1 | 0 | 0 | 0 | 0 | 0 | – | 0 | 0 | 1 | 0 | 0 | 0 | 0 | 0 |
| Bud Site | 0 | 0 | 0 | 0 | 0 | 0 | 0 | 0 | 0 | 0 | 0 | 0 | 0 | 0 | 0 | – | 0 | 0 | – | – | – | – | – | – |
| Cell Periphery | 0 | 1 | 1 | 1 | 3 | 3 | 4 | 1 | 1 | 1 | 3 | 0 | 0 | 1 | 2 | – | 2 | 5 | 0 | 0 | 0 | 0 | 0 | 0 |
| Cytoplasm | 103 | 65 | 88 | 125 | 117 | 128 | 193 | 276 | 155 | 179 | 82 | 101 | 17 | 200 | 262 | – | 75 | 111 | 102 | 90 | 82 | 99 | 160 | 210 |
| Endoplasmic Reticulum | 4 | 3 | 1 | 0 | 0 | 0 | 1 | 0 | 2 | 0 | 0 | 2 | 0 | 2 | 1 | – | 2 | 11 | 4 | 1 | 7 | 0 | 1 | 3 |
| Endosome | 0 | 0 | 0 | 0 | 0 | 2 | 5 | 2 | 0 | 1 | 1 | 0 | 0 | 1 | 1 | – | 0 | 0 | 1 | 1 | 1 | 0 | 0 | 4 |
| Golgi | 0 | 0 | 0 | 0 | 0 | 0 | 0 | 0 | 0 | 0 | 0 | 0 | 0 | 0 | 0 | – | 0 | 1 | 0 | 0 | 0 | 0 | 0 | 0 |
| Mitochondria | 9 | 14 | 0 | 9 | 7 | 23 | 24 | 47 | 105 | 109 | 92 | 109 | 0 | 0 | 0 | – | 3 | 3 | 5 | 8 | 17 | 3 | 3 | 6 |
| Nucleus | 0 | 0 | 1 | 3 | 4 | 2 | 2 | 4 | 2 | 2 | 3 | 4 | 0 | 0 | 0 | – | 0 | 0 | 0 | 0 | 0 | 0 | 0 | 0 |
| Nuclear Periphery | 1 | 1 | 0 | 0 | 0 | 0 | 0 | 0 | 1 | 1 | 0 | 0 | 1 | 0 | 1 | – | 0 | 0 | 0 | 0 | 0 | 0 | 0 | 0 |
| Nucleolus | 0 | 0 | 0 | 1 | 2 | 0 | 0 | 0 | 1 | 0 | 1 | 0 | 0 | 0 | 0 | – | 0 | 0 | 0 | 0 | 0 | 0 | 0 | 0 |
| Peroxisomes | 0 | 0 | 0 | 0 | 0 | 0 | 0 | 1 | 0 | 0 | 0 | 0 | 0 | 0 | 0 | – | 0 | 0 | 0 | 0 | 1 | 0 | 0 | 0 |
| SpindlePole | 0 | 0 | 0 | 0 | 0 | 0 | 0 | 2 | 1 | 0 | 1 | 0 | 0 | 0 | 0 | – | 0 | 0 | 0 | 0 | 0 | 0 | 1 | 2 |
| Vac/Vac Membrane | 0 | 0 | 0 | 2 | 2 | 5 | 6 | 10 | 3 | 2 | 1 | 2 | 0 | 0 | 1 | – | 0 | 3 | 3 | 2 | 3 | 1 | 2 | 4 |
| Unique Cell Count | 110 | 76 | 89 | 132 | 125 | 144 | 214 | 312 | 216 | 244 | 140 | 172 | 18 | 203 | 265 | 76 | 119 | 122 | 107 | 119 | 109 | 180 | 245 | |
| Labelled Cell Count | 119 | 85 | 92 | 142 | 135 | 163 | 236 | 344 | 280 | 301 | 188 | 220 | 18 | 204 | 268 | 82 | 135 | 122 | 107 | 119 | 109 | 180 | 245 | |
Yeast GFP Assignment
Protein Abundance
| Screen | WT1 | WT2 | WT3 | RAP60 | RAP140 | RAP220 | RAP300 | RAP380 | RAP460 | RAP540 | RAP620 | RAP700 | HU80 | HU120 | HU160 | rpd3Δ_1 | rpd3Δ_2 | rpd3Δ_3 | AF100 | AF140 | AF180 |
|---|---|---|---|---|---|---|---|---|---|---|---|---|---|---|---|---|---|---|---|---|---|
| Mean Cell GFP Intensity (1e-4) | 5.0 | 3.8 | 5.6 | 5.3 | 6.3 | 5.2 | 5.2 | 5.4 | 4.2 | 4.5 | 4.2 | 4.2 | 4.8 | 6.2 | 5.6 | 4.2 | 5.2 | 5.8 | 6.3 | 6.7 | 6.6 |
| Std Deviation (1e-4) | 0.7 | 0.6 | 1.2 | 1.3 | 1.8 | 1.6 | 1.4 | 1.9 | 1.1 | 1.3 | 1.3 | 1.0 | 0.5 | 2.2 | 1.5 | 0.8 | 0.8 | 1.3 | 1.5 | 1.9 | 1.9 |
| Intensity Change (Log2) | – | – | – | -0.06 | 0.18 | -0.09 | -0.1 | -0.03 | -0.42 | -0.31 | -0.4 | -0.42 | -0.21 | 0.17 | 0.01 | -0.42 | -0.09 | 0.05 | 0.18 | 0.27 | 0.25 |
Localization Change
| Localization | RAP60 | RAP140 | RAP220 | RAP300 | RAP380 | RAP460 | RAP540 | RAP620 | RAP700 | HU80 | HU120 | HU160 | rpd3Δ_1 | rpd3Δ_2 | rpd3Δ_3 |
|---|---|---|---|---|---|---|---|---|---|---|---|---|---|---|---|
| Actin | – | – | – | – | – | – | – | – | – | – | – | – | – | – | – |
| Bud | – | – | – | – | – | – | – | – | – | – | – | – | – | – | – |
| Bud Neck | – | – | – | – | – | – | – | – | – | – | – | – | – | – | – |
| Bud Site | – | – | – | – | – | – | – | – | – | – | – | – | – | – | – |
| Cell Periphery | – | – | – | – | – | – | – | – | – | – | – | – | – | – | – |
| Cyto | – | – | – | – | – | – | – | – | – | – | – | – | – | – | – |
| Endoplasmic Reticulum | – | – | – | – | – | – | – | – | – | – | – | – | – | – | – |
| Endosome | – | – | – | – | – | – | – | – | – | – | – | – | – | – | – |
| Golgi | – | – | – | – | – | – | – | – | – | – | – | – | – | – | – |
| Mitochondria | – | – | – | – | – | – | – | – | – | – | – | – | – | – | – |
| Nuclear Periphery | – | – | – | – | – | – | – | – | – | – | – | – | – | – | – |
| Nuc | – | – | – | – | – | – | – | – | – | – | – | – | – | – | – |
| Nucleolus | – | – | – | – | – | – | – | – | – | – | – | – | – | – | – |
| Peroxisomes | – | – | – | – | – | – | – | – | – | – | – | – | – | – | – |
| SpindlePole | – | – | – | – | – | – | – | – | – | – | – | – | – | – | – |
| Vac | – | – | – | – | – | – | – | – | – | – | – | – | – | – | – |
| Cortical Patches | – | – | – | – | – | – | – | – | – | – | – | – | – | – | – |
| Cytoplasm | – | – | – | – | – | – | – | – | – | – | – | – | – | – | – |
| Nucleus | – | – | – | – | – | – | – | – | – | – | – | – | – | – | – |
| Vacuole | – | – | – | – | – | – | – | – | – | – | – | – | – | – | – |
External localization resources
Images






























Protein Concentration and Protein Localization Data
| R1 | R2 | R3 | ||||||||||||||||
|---|---|---|---|---|---|---|---|---|---|---|---|---|---|---|---|---|---|---|
| G1 Pre-START | G1 Post-START | S/G2 | Metaphase | Anaphase | Telophase | G1 Pre-START | G1 Post-START | S/G2 | Metaphase | Anaphase | Telophase | G1 Pre-START | G1 Post-START | S/G2 | Metaphase | Anaphase | Telophase | |
| Concentration | -0.4919 | 0.2012 | -0.0478 | -0.0705 | -0.0708 | 0.089 | 2.5487 | 3.3523 | 3.2322 | 2.8434 | 3.512 | 3.5524 | 0.0952 | 0.8477 | 0.5316 | 1.092 | 0.3859 | 0.6793 |
| Actin | 0.004 | 0.0006 | 0.0008 | 0.0075 | 0.0259 | 0.007 | 0.0339 | 0.0028 | 0.0081 | 0.0003 | 0.0236 | 0.0052 | 0.0078 | 0.0014 | 0.011 | 0.0114 | 0.0292 | 0.0014 |
| Bud | 0.0005 | 0.0006 | 0.0027 | 0.0003 | 0.0003 | 0.0006 | 0.0006 | 0.0008 | 0.0026 | 0.0008 | 0.0017 | 0.0006 | 0.0005 | 0.0002 | 0.0014 | 0.0013 | 0.0003 | 0 |
| Bud Neck | 0.0017 | 0.0003 | 0.0002 | 0.0002 | 0.0009 | 0.0039 | 0.0101 | 0.0001 | 0.0003 | 0.0004 | 0.0016 | 0.0007 | 0.0004 | 0.0009 | 0.0001 | 0.0005 | 0.0004 | 0.0003 |
| Bud Periphery | 0.0005 | 0.0005 | 0.0053 | 0.0003 | 0.0005 | 0.0006 | 0.001 | 0.0013 | 0.0057 | 0.0006 | 0.0032 | 0.001 | 0.0007 | 0.0002 | 0.0033 | 0.0017 | 0.0004 | 0 |
| Bud Site | 0.0066 | 0.0033 | 0.0015 | 0.0004 | 0.0008 | 0.0006 | 0.0085 | 0.0012 | 0.0026 | 0.0006 | 0.0102 | 0.0002 | 0.001 | 0.0128 | 0.0004 | 0.0008 | 0.0003 | 0 |
| Cell Periphery | 0.0003 | 0.0003 | 0.0003 | 0.0002 | 0.0002 | 0.0002 | 0.0003 | 0.0002 | 0.0003 | 0.0003 | 0.0006 | 0.0001 | 0.0004 | 0.0003 | 0.0002 | 0.0002 | 0.0001 | 0.0001 |
| Cytoplasm | 0.4974 | 0.5701 | 0.5475 | 0.5576 | 0.4207 | 0.6537 | 0.2884 | 0.5126 | 0.364 | 0.4274 | 0.3001 | 0.4376 | 0.3633 | 0.5524 | 0.596 | 0.5115 | 0.569 | 0.6783 |
| Cytoplasmic Foci | 0.0259 | 0.0263 | 0.0172 | 0.0285 | 0.0516 | 0.0335 | 0.0389 | 0.0119 | 0.0159 | 0.0139 | 0.0164 | 0.0104 | 0.0277 | 0.0155 | 0.0071 | 0.0275 | 0.0075 | 0.0105 |
| Eisosomes | 0.0004 | 0.0001 | 0.0001 | 0.0033 | 0.0016 | 0.0001 | 0.0004 | 0.0002 | 0.0002 | 0.0001 | 0.0002 | 0.0001 | 0.0001 | 0.0001 | 0.0001 | 0.0001 | 0.0001 | 0.0001 |
| Endoplasmic Reticulum | 0.0069 | 0.0031 | 0.0053 | 0.003 | 0.0026 | 0.0037 | 0.0023 | 0.0016 | 0.0057 | 0.0022 | 0.0029 | 0.0023 | 0.0056 | 0.0026 | 0.003 | 0.0052 | 0.0046 | 0.0025 |
| Endosome | 0.0151 | 0.0171 | 0.0165 | 0.0619 | 0.0233 | 0.015 | 0.0129 | 0.0031 | 0.0079 | 0.0152 | 0.0101 | 0.0089 | 0.0246 | 0.0022 | 0.0053 | 0.0403 | 0.0112 | 0.0063 |
| Golgi | 0.0015 | 0.001 | 0.0016 | 0.0019 | 0.0034 | 0.001 | 0.0046 | 0.0009 | 0.0015 | 0.0004 | 0.0035 | 0.0014 | 0.0077 | 0.0005 | 0.0033 | 0.0069 | 0.0056 | 0.0012 |
| Lipid Particles | 0.003 | 0.0008 | 0.0013 | 0.0038 | 0.0093 | 0.0013 | 0.0077 | 0.0018 | 0.0014 | 0.0002 | 0.0043 | 0.0011 | 0.0249 | 0.0007 | 0.0006 | 0.003 | 0.0016 | 0.0054 |
| Mitochondria | 0.001 | 0.0005 | 0.0013 | 0.0015 | 0.0134 | 0.0007 | 0.0014 | 0.0007 | 0.0028 | 0.0005 | 0.0014 | 0.0013 | 0.0027 | 0.0003 | 0.0069 | 0.0036 | 0.0017 | 0.0004 |
| None | 0.4244 | 0.3665 | 0.3895 | 0.3201 | 0.4021 | 0.2727 | 0.5512 | 0.4566 | 0.57 | 0.5274 | 0.5699 | 0.5232 | 0.5149 | 0.4033 | 0.3572 | 0.3533 | 0.3645 | 0.2902 |
| Nuclear Periphery | 0.0019 | 0.0008 | 0.0014 | 0.0008 | 0.0011 | 0.0008 | 0.0057 | 0.0003 | 0.0031 | 0.0006 | 0.0055 | 0.0023 | 0.0034 | 0.0003 | 0.0006 | 0.0028 | 0.0008 | 0.0004 |
| Nucleolus | 0.0005 | 0.0003 | 0.0002 | 0.0001 | 0.0006 | 0.0001 | 0.0008 | 0.0001 | 0.0002 | 0.0002 | 0.0008 | 0.0001 | 0.0003 | 0.0001 | 0 | 0.0001 | 0 | 0 |
| Nucleus | 0.0012 | 0.0015 | 0.0013 | 0.0008 | 0.0018 | 0.0009 | 0.0041 | 0.0006 | 0.0013 | 0.001 | 0.0207 | 0.0006 | 0.0008 | 0.0004 | 0.0006 | 0.001 | 0.0004 | 0.0004 |
| Peroxisomes | 0.0023 | 0.0002 | 0.0002 | 0.0021 | 0.0163 | 0.0004 | 0.0155 | 0.001 | 0.0019 | 0.0002 | 0.0031 | 0.0006 | 0.0069 | 0.0044 | 0.0004 | 0.0206 | 0.0004 | 0.0011 |
| Punctate Nuclear | 0.0018 | 0.0008 | 0.0009 | 0.0005 | 0.0209 | 0.001 | 0.0078 | 0.0005 | 0.0019 | 0.0005 | 0.0188 | 0.0011 | 0.0022 | 0.0006 | 0.0002 | 0.0008 | 0.0003 | 0.0006 |
| Vacuole | 0.0028 | 0.0049 | 0.0041 | 0.0044 | 0.002 | 0.0019 | 0.0035 | 0.0015 | 0.0019 | 0.0062 | 0.0011 | 0.001 | 0.0031 | 0.001 | 0.0021 | 0.006 | 0.0012 | 0.0006 |
| Vacuole Periphery | 0.0004 | 0.0006 | 0.0007 | 0.001 | 0.0006 | 0.0004 | 0.0006 | 0.0002 | 0.0005 | 0.0008 | 0.0003 | 0.0004 | 0.0009 | 0.0001 | 0.0002 | 0.0014 | 0.0003 | 0.0001 |
Sequencing Data
| R1 | R2 | |||||||||
|---|---|---|---|---|---|---|---|---|---|---|
| G1 Post-START | S/G2 | Metaphase | Anaphase | Telophase | G1 Post-START | S/G2 | Metaphase | Anaphase | Telophase | |
| Gene Expression | – | – | – | – | – | – | – | – | – | – |
| Translational Efficiency | – | – | – | – | – | – | – | – | – | – |
Hit Data
| Dataset | Hit |
|---|---|
| Protein Concentration | ✔ |
| Protein Localization | ✘ |
| Gene Expression | – |
| Translational Efficiency | – |
Endocytosis
| Temp | Actin Patch (Sac6-tdTomato) | Cortical Patch (Sla1-GFP) | Late Endosome (Snf7-GFP) | Vacuole (Vph1-GFP) |
|---|---|---|---|---|
| 37℃ | ||||
| RT |
Cell Cycle Omics
CYCLoPs (Yjr011c-GFP)
| Gene / Allele | Actin Patch (Sac6-tdTomato) | Cortical Patch (Sla1-GFP) | Late Endosome (Snf7-GFP) | Vacuole (Sac6-tdTomato) |
|---|
| Gene | Images |
|---|
| Gene | Images |
|---|
Images are not yet available
Images are not yet available